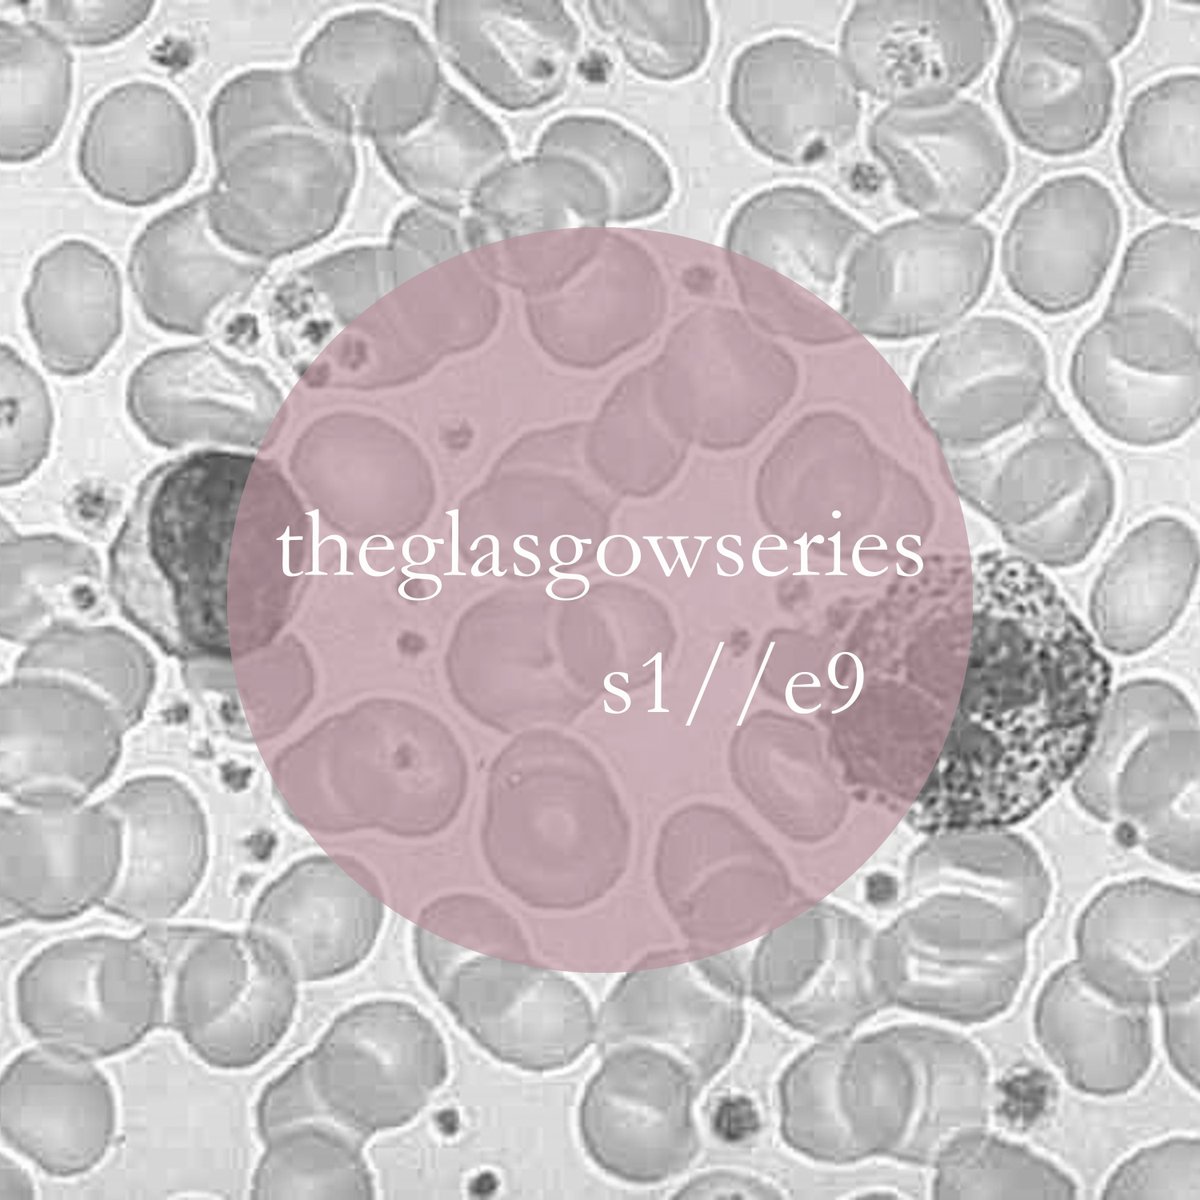
Today's episode features Professor Anthony Chalmers, consultant clinical oncologist. He presents an incredible story of success for a lady affected by brain cancer and explores the fundamental role of clinical trials in oncology @ProfAJChalmers @CRUK_BI <a href="/Beatson_Charity/">Beatson Cancer Charity</a>
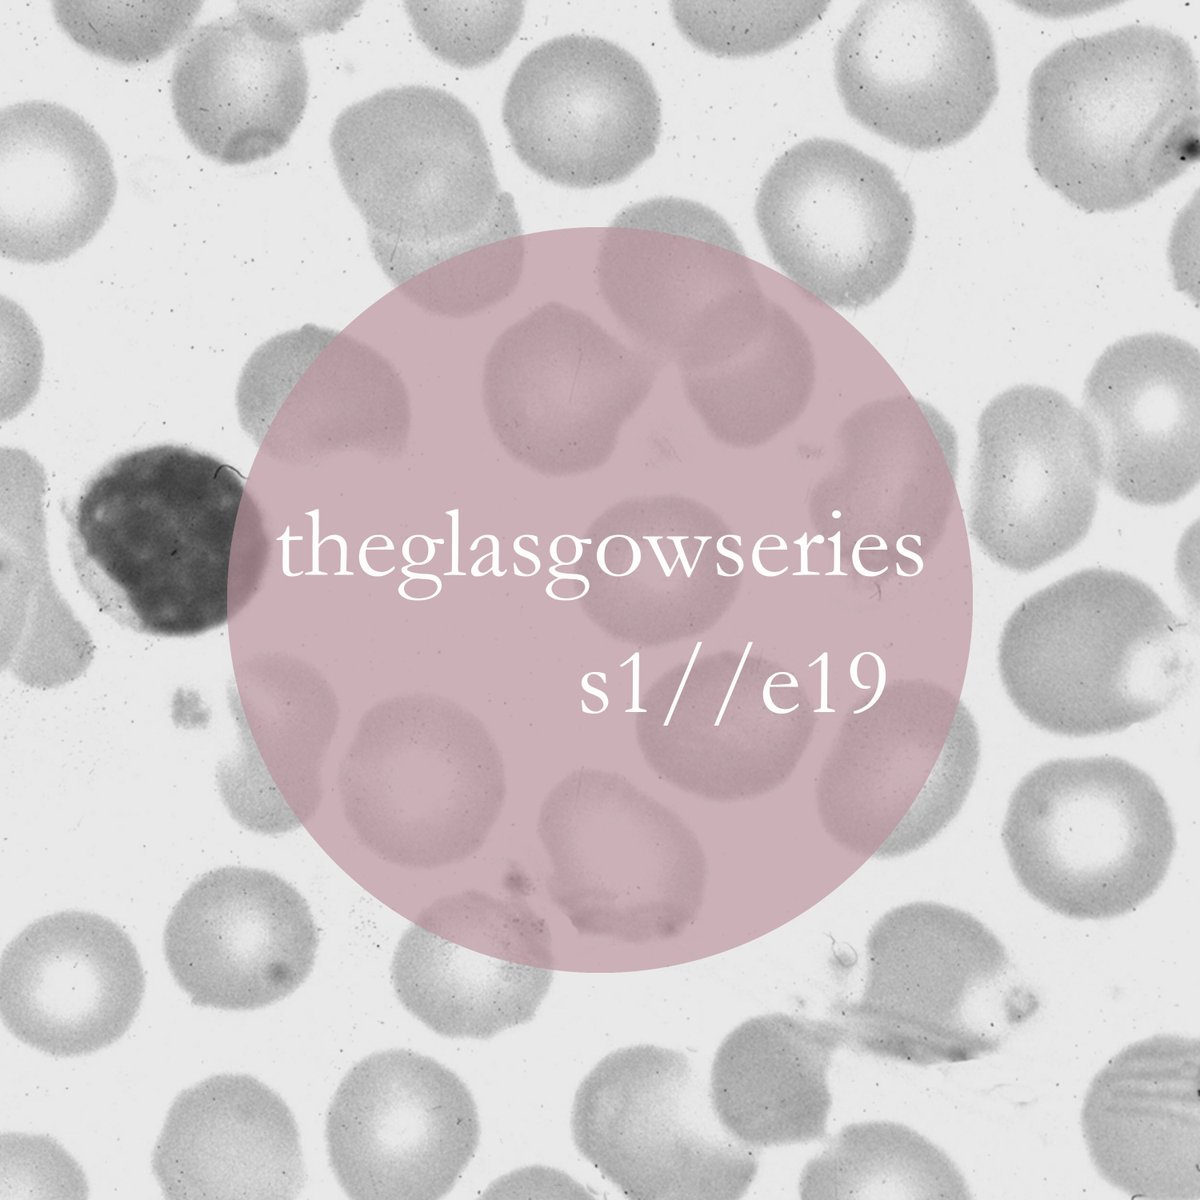
Get ready to be convinced that you want to become a Pathologist! Dr Sioban Fraser, Consultant Pathologist, QEUH wholly inspired me this week to think about a career in diagnostics... Have a listen! <a href="/pathsoc/">Pathological Society</a> <a href="/RCPath/">RC of Pathologists</a>  <a href="/NHS_Education/">NHS Education for Scotland (NES)</a> <a href="/QEUHMedicine/">Medicine Students</a> #MedEd #MedicalEducation #Pathology

theglasgowseries
@theglasgowseri1
The Glasgow Series
Podcasts by junior doctors for junior doctors.
Inspirational clinicians // Memorable cases // Junior doctor led
Instagram: @theglasgowseries
ID: 1363773390272790530
http://theglasgowseries.co.uk 22-02-2021 08:51:58
39 Tweet
233 Followers
59 Following

Here's the latest episode of my podcast - theglasgowseries - where I talk all things haematology with Dr Ted Fitzsimons! Have a listen! theglasgowseries #haematology #MedTwitter open.spotify.com/episode/2grDPg…

We've got a new episode for you tomorrow... we talk to Dr Andrew Fraser, Consultant gastroenterologist, QEUH. Tune in on Spotify or at theglasgowseries.co.uk Medicine Students #gastroenterology #theglasgowseries


Today's episode features Professor Anthony Chalmers, consultant clinical oncologist. He presents an incredible story of success for a lady affected by brain cancer and explores the fundamental role of clinical trials in oncology @ProfAJChalmers @CRUK_BI Beatson Cancer Charity

Tune in today to hear from Dr Bell, Consultant in Infectious Diseases and Acute Medicine, as he teaches us an important lesson involving fever and confusion.... David Bell #InfectiousDisease #medicaleducation



We are back! With a wonderful episode from Dr Hilary Wilson, Consultant Rheumatologist. We discuss a touching case of a young man with inflammatory arthritis and her well-travelled career! Friends of Glasgow Royal Infirmary @hilarywilson111





Today on the podcast we have Mr Nigel Jamieson, Consultant Hepatobiliary Surgeon at the GRI. We discuss the case of a young woman who receives a Whipple procedure for pancreatic cancer, as well as a career as an academic surgeon! Nigel B. Jamieson Surgery Glasgow Royal Infirmary GPeriop



Thanks Medic Insight EdinburghGLA @medicinsight for the invitation to speak today about surgery. It was Incredible to see 110 pupils on the zoom call. They really were Fantastic questions. I hope you found it useful. UofG MVLS UofG Medicine Cancer Research UK in Scotland Surgery Glasgow Royal Infirmary theglasgowseries


Tune in for Dr Jason Mannix, Consultant Psychiatrist at the GRI, presenting a case of a young woman with emotionally unstable personality disorder and how best to approach this as a clinician Surgery Glasgow Royal Infirmary Friends of Glasgow Royal Infirmary GRI Surgery Education #theglasgowseries #medicaleducation #podcast


Join us today with Dr Susie Daisley, consultant in Intensive Care and Emergency Medicine, QEUH. She shares a touching case, highlighting the importance of early recognition of a deteriorating patient, and to always make the most of everyday! QEUH ED Wellbeing QEUH Department of Anaesthesia, Glasgow, UK


Join us today with Dr Jude Morris, Consultant Gastroenterologist, QEUH. She discusses not letting an illness define a patient’s choices and life, and how we must adapt our services to support them in that #medicaleducation #podcast Surgery QEUH Medicine Students GRI Endoscopy


Get ready to be convinced that you want to become a Pathologist! Dr Sioban Fraser, Consultant Pathologist, QEUH wholly inspired me this week to think about a career in diagnostics... Have a listen! Pathological Society RC of Pathologists NHS Education for Scotland (NES) Medicine Students #MedEd #MedicalEducation #Pathology

Today we release the final episode of Season 1 - Dr Mark Hall talks about the events that led him to a career in radiology. Thank you for all of your support along this journey-we hope podcasts will become a regular feature in MedEd! #meded #podcast #radiology The Royal College of Radiologists


New podcast theglasgowseries for junior doctors, set up by two foundation trainees during the pandemic. Episodes feature interviews with clinicians reflecting on memorable cases. Check out season one, now available on theglasgowseries.co.uk and on Spotify @scotmedtraining





